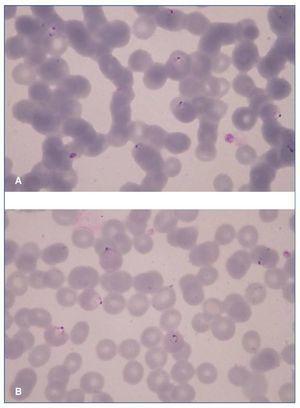

INTRODUCCIÓN
Los receptores de trasplante de órgano sólido son particularmente vulnerables a las enfermedades infecciosas, que son una importante causa de morbimortalidad. Se estima que más del 80% de estos pacientes ha sufrido al menos un episodio en el primer año. Las infecciones más comunes en el postrasplante inmediato son las nosocomiales, pero no hay que olvidar las que pueden haber sido transmitidas por el injerto. Un diagnóstico y un tratamiento precoces marcarán el pronóstico del paciente1.
CASO CLÍNICO
Paciente de 42 años, de origen nigeriano pero residente en España desde hacía 12 años, con un último viaje a su país hacía 5 años. Recibe trasplante renal de donante vivo ABO compatible genéticamente relacionado (hermano) HLA idéntico.
En el estudio pretrasplante renal del receptor destacaba enfermedad renal crónica de origen no filiado en programa de hemodiálisis durante 27 meses, hipertensión arterial controlada con 2 fármacos e infección por virus de la hepatitis C (VHC) genotipo 1B, con carga viral positiva pero sin alteración funcional y con una elastografía con bajo grado de fibrosis (0-1), para la que se había optado por tratamiento postrasplante.
El donante de 54 años, su hermano HLA idéntico y residente en Nigeria, no presentaba contraindicaciones en la evaluación predonación. Se había trasladado para completar los estudios 2 meses antes del trasplante permaneciendo asintomático en este período. Refería un último episodio de malaria hacía años.
Dentro del cribado infeccioso pretrasplante/donación presentaban, tanto donante como receptor, Mantoux positivos y serologías para citomegalovirus (CMV), virus del herpes simple, virus de Epstein-Barr y virus de la varicela zóster IgG positivas. Además, los resultados serológicos para Leishmania spp., Strongyloides spp. (mediante ELISA), Schistosoma spp., Plasmodium spp. (mediante reacción en cadena de la polimerasa [PCR]), virus de la leucemia/linfoma de células T humanas-I/II, y parásitos en heces y orina fueron negativos en ambos.
Tanto la nefrectomía derecha como el trasplante transcurrieron sin incidencias, y no requirieron transfusión de hemoderivados. El receptor recibió inmunosupresión con basiliximab, tacrolimus, micofenolato y pauta de suspensión precoz de esteroides. La profilaxis infecciosa se llevó a cabo con valganciclovir, trimetoprim-sulfametoxazol e isoniacida (Mantoux positivo).
El trasplante evolucionó con función renal inmediata y creatinina al alta de 1,78 mg/dl (aclaramiento de creatinina, 82 ml/min). Como complicaciones en el ingreso presentó: seroma en región anterior al injerto, que fue drenado, y diabetes mellitus postrasplante (a pesar de sobrecarga oral de glucosa pretrasplante normal) probablemente asociado a VHC positivo con tacrolimus y raza negra.
A los 21 días del trasplante acude al servicio de urgencias por síndrome febril con disuria leve, postración y cefalea de 48 h de evolución. A la exploración física únicamente se objetivó un injerto renal en fosa ilíaca derecha ligeramente aumentado de tamaño. En la analítica destacaba: anemización (hemoglobina, 9,4 frente a 12,6 g/dl); fórmula leucocitaria con desviación izquierda sin leucocitosis franca; trombopenia llamativa (33.000/µl); leve deterioro de la función renal (creatinina 2 mg/dl), con sedimento urinario normal; bilirrubina total, 1,8 mg/dl, con bilirrubina indirecta, 1,4 mg/dl; lactatodeshidrogenasa, 332 U/l; procalcitonina, 1,46 ng/ml; transaminasas normales o en límite superior de la normalidad; coagulación normal, y test de gripe negativo. Se realizó una ecografía Doppler del trasplante, donde se observa recidiva de la colección periinjerto sin otros hallazgos de interés.
El paciente ingresa a las pocas horas en planta de hospitalización con diagnóstico de posible sepsis secundaria a pielonefritis del injerto +/– colección sobreinfectada y para ampliar estudio de anemia hemolítica en postrasplante inmediato.
En analítica solicitada al servicio de hematología se comprueba anemia con reticulocitos aumentados y test de Coombs directo negativo. La haptoglobina en este caso fue normal. El frotis sanguíneo no demostró esquistocitos, pero se visualizaron ejemplares de Plasmodium falciparum intraeritrocitarios, con grado de parasitemia > 5% (fig. 1A y B); dicho resultado se confirmó mediante PCR anidado (nested PCR). El mismo estudio por nested PCR fue llevado a cabo en el donante que permanecía asintomático, repitiéndose en su caso el resultado negativo.
Figura 1. A y B) Frotis sanguíneo con parásitos intraeritrocitarios en fase de trofozoito.
Al realizarse el diagnóstico de malaria, el paciente cumplía 4 de los 10 criterios de gravedad (parasitemia > 5%, anemia grave, trombopenia e insuficiencia renal aguda). Los criterios de gravedad que no presentó fueron hipoglucemia, acidosis metabólica, coagulopatía, insuficiencia hepática, alteraciones neurológicas o síndrome de distrés respiratorio del adulto.
Se inició tratamiento inmediato con Quinimax® y doxiclina y se suspendió el tratamiento empírico con ciprofloxacino tras la llegada del urocultivo negativo. El tratamiento se mantuvo durante 7 días con evolución favorable. Los hemocultivos y la PCR de CMV fueron igualmente negativos.
A las 48 h, el paciente se encontraba asintomático con mejoría analítica. La parasitemia descendió al 1% tras 2 días de tratamiento. Fue < 1% al cuarto día y se negativizó al séptimo día. En el momento del alta, la cifra de hemoglobina y plaquetas se había normalizado y la función del injerto, que se había deteriorado hasta una creatinina máxima de 2,8 mg/dl, regresó a sus cifras basales (fig. 2A y B).
Figura 2. A y B) Evolución analítica pre- y postratamiento.
DISCUSIÓN
Se describe el caso de un receptor de trasplante renal de donante vivo con malaria en el postrasplante inmediato, a pesar de PCR negativas para Plasmodium spp., tanto en donante como en receptor, en el pretrasplante y persistentemente negativa en el donante en el postrasplante. Se barajó la opción de una infección submicroscópica transmitida por el órgano trasplantado o bien reactivada desde una situación de latencia en el propio receptor.
En casos como este, el pronóstico y la evolución posterior del paciente dependen de un diagnóstico y un tratamiento precoces. La anemia hemolítica en el postrasplante nos sitúa ante un amplio abanico de posibilidades etiológicas.
En este caso, el Coombs directo negativo descartaba hemólisis asociada a causas inmunológicas (anticuerpos frente a la membrana del eritrocito). Un frotis normal nos habría obligado a investigar hiperesplenismo, hepatopatías o hemoglobinuria paroxística nocturna. Por otra parte, un frotis con esquistocitos (tampoco era el caso) nos hubiese orientado hacia las distintas etiologías de una microangiopatía trombótica (incluyendo si cabe la asociación que esta podría tener con la infección por VHC2, tratamiento con tacrolimus o una posible inmunoactivación). Sin embargo, en este caso, con un síndrome febril asociado y presencia de parásitos intraeritrocitarios en fase de trofozoito en el frotis de sangre periférica, el diagnóstico no presentó dudas.
La malaria es una enfermedad grave producida por el parásito Plasmodium spp. y transmitida por el mosquito Anopheles. Constituye un importante problema de salud, especialmente en áreas tropicales y subtropicales.
Las especies de Plasmodium que producen malaria en el ser humano son P. falciparum, P. vivax, P. ovale y P. malariae. En algunas especies de Plasmodium, el esquizonte hepático puede permanecer en estado latente en forma de hipnozoito y la reactivación de los hipnozoitos puede ocurrir muchos años después de la infección inicial. Entre las especies que forman hipnozoitos están P. ovale y P. vivax.P. falciparum, que por otra parte es la variante más letal, no da lugar a reactivaciones. Su período de incubación varía entre 8 y 25 días, pero puede ampliarse si el huésped presenta algún grado de inmunidad.
El paludismo se caracteriza por paroxismos febriles con anemia hemolítica, trombopenia y síntomas gripales. La afectación sistémica no es infrecuente, sobre todo en los casos de P. falciparum, y puede producir edema pulmonar no cardiogénico, afectación del sistema nervioso central, fracaso renal agudo, hipoglucemias, acidosis metabólica y coinfecciones.
En regiones endémicas existe una alta tasa de población con infección asintomática debido a parasitemia submicroscópica. Esto se debe a que las infecciones repetidas pueden dar lugar a cambios en la respuesta inmune y conferir protección frente a la malaria clínica3-5.
En zonas donde la malaria es prevalente, determinadas hemoglobinopatías como la drepanocitosis (anemia falciforme de herencia autosómica recesiva) o el rasgo drepanocítico (mutación en heterocigosis) confieren cierta protección a padecer malaria clínica por distintos mecanismos6. A diferencia de la anemia falciforme, los pacientes con rasgo drepanocítico no suelen presentar grandes problemas clínicos asociados a su alteración sanguínea; sin embargo, ante determinadas circunstancias extenuantes podrían sufrir complicaciones como infarto esplénico o necrosis papilar. Por este motivo, en algunos centros de trasplante con alta prevalencia de población afectada se estudia por sistema a los donantes vivos y en determinados programas se excluyen como tales a los pacientes con rasgo drepanocítico7.
La microscopia (gota gruesa) es el método convencional para el diagnóstico de Plasmodium spp., pero existen otras técnicas como detección rápida por inmunocromatografía y la PCR. La PCR (nested PCR y RT-PCR) es superior a la microscopia para la detección de infecciones mixtas y de bajo grado y se considera para estos casos el gold standard, con una elevada sensibilidad8.
Siguiendo las recomendaciones9, tanto donante como receptor fueron estudiados antes del trasplante con la técnica de mayor sensibilidad diagnóstica para paludismo (el donante con 2 tipos de PCR), siendo todos los resultados negativos. A pesar de esto, el receptor desarrolló malaria tras el trasplante, lo que confirma la limitación de la técnica de cribado en casos de infección subclínica10.
En los países sin endemismo, los casos de malaria que se diagnostican son esporádicos y se relacionan con los fenómenos migratorios, viajeros, transfusiones o con el trasplante de órgano sólido11,12.
Los casos de paludismo en pacientes trasplantados no son frecuentes en nuestro medio, pero están descritos. Se han publicado casos principalmente de trasplantes renales, pero también de otros trasplantes de órgano sólido, médula ósea y en casos de donaciones multiorgánicas11,13-21.
CONCLUSIONES
• Tanto en donantes como en receptores de trasplante renal de donante vivo de áreas endémicas es necesario llevar a cabo cribado de paludismo mediante PCR.
• Dadas las limitaciones de estas técnicas en los casos de infecciones de bajo grado subclínicas, debería considerarse el tratamiento del donante/receptor previo al trasplante.
• Aunque sin evidencias sólidas sobre el pronóstico de receptores/donantes con rasgo drepanocítico, en donantes vivos de áreas con malaria endémica o sus descendientes debería conocerse el estado de portador de cara a informar sobre posibles riesgos.
Conflictos de interés
Los autores declaran que no tienen conflictos de interés potenciales relacionados con los contenidos de este artículo.
Correspondencia:
A. González Rinne
Servicio de Nefrología. Hospital Universitario de Canarias.
Ofra, s/n.
38320 San Cristobal de La Laguna. Santa Cruz de Tenerife. Islas Canarias. España.
anamaria.gonzalez.rinne@gmail.com